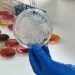
Favet crea Certificación de Calidad e Inocuidad de los Alimentos

La empresa de soluciones logísticas refrigeradas IceStar, ligada al fondo brasileño Patria Investments, dio un paso decisivo en su estrategia de expansión en Chile. Recientemente concretó la compra del 100 % de Mega Frío Chile, en una operación valorizada en $55 mil millones (unos US$ 57 millones), según informó Diario Financiero.
Con esta adquisición, la firma alcanzó una capacidad total de 1,1 millones de metros cúbicos de almacenaje. “Somos la compañía frigorífica más grande de Chile”, aseguró su gerente general en el país, Jean Falotico, al medio económico. Desde la misma empresa afirmaron que “todavía hay muchas oportunidades en el país”.
IceStar ya opera en distintos puntos del territorio, incluyendo Puerto Montt, y avanza en un proceso de integración de 100 días liderado por Patria, PwC y ejecutivos locales. Al término de ese plazo, toda la operación funcionará bajo la marca IceStar. “Sacar lo mejor de los dos mundos”, declaró Falotico.
Nueva inversión en Coronel: foco en el salmón y productos del mar
En este proceso, la empresa anunció una inversión de US$30 millones para levantar un moderno frigorífico en Coronel, región del Biobío, principal punto de embarque de contenedores refrigerados en el sur del país. El proyecto contempla una capacidad de 40 mil posiciones de pallets y apunta a exportadores de productos del mar, entre ellos, el salmón, además de fruta congelada.
Este nuevo centro forma parte de una hoja de ruta más amplia. IceStar proyecta invertir US$750 millones en América Latina de aquí a 2027, con la meta de consolidarse como el líder regional en logística frigorífica.
El pasado abril, la empresa inauguró la primera etapa del frigorífico en Coronel. Esta fase, ya operativa, dispone de 16 mil posiciones de pallets, mientras que la segunda etapa, que sumará otras 24 mil, se completará en 2026.
En sus instalaciones, IceStar cuenta con compresores de respaldo, generadores de alta capacidad y racks metálicos, elementos que aseguran continuidad operativa y mayor velocidad en los despachos. Además, la empresa ofrecerá servicios como carga y descarga, túneles de congelación, etiquetado, cross docking, inventarios y andenes refrigerados conectados directamente a camiones. Todo esto “asegura eficiencia, inocuidad y trazabilidad en todo momento”, afirman desde IceStar.
Con estas apuestas, la compañía busca atender de forma integral a sectores clave de la economía exportadora chilena, como el acuícola y frutícola.